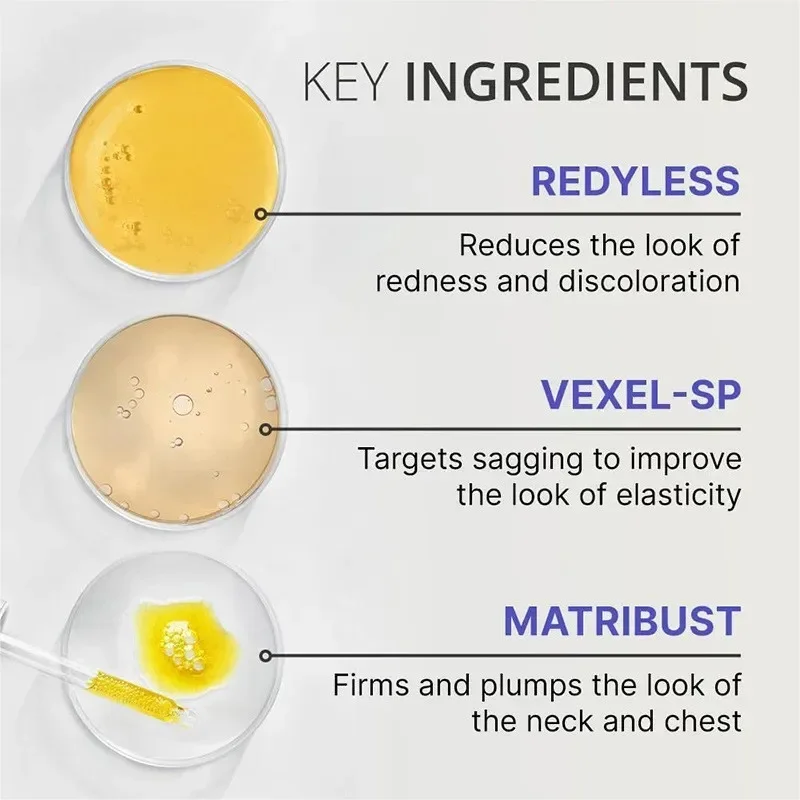
thumb

50 мл крем для шеи лифтинг лица лифтинг Осветляющий сглаживающий Уход Лосьон увлажняющий крем для шеи крем для омоложения шеи
Price history chart & currency exchange rate
Customers also viewed

$30.74
Для автомобиля клуба, прецедент 2015, зарядное устройство, аксессуары для Subaru EX40 105137401, детали для гольф-мобиля
aliexpress.ru
$25.38
Запястье в стиле аниме для мужчин и женщин, подъемные ремни борсерка, мягкие ремни на запястье для тяжелой атлетики, тренировок в тренажерном зале, пауэрлифтинга
aliexpress.ru
$33.65
25-нотный ксилофон, алюминиевая пластина, фортепиано с ручным стуком, чехол из АБС-пластика, перкуссия, ритм, музыкальное образовательное обучение для детей
aliexpress.ru
$5.36
Обновленный адаптер кронштейна гидравлического тормоза для аксессуаров для скутеров Xiaomi M365/M365 Pro Xtech
aliexpress.ru
$5.76
10 Packs Guitar Nylon Strings Accessories Parts Supply Supplies Accessory The Cross
aliexpress.ru
$7.07
Flag Of Corsica Neck Gaiter Women Men Windproof Winter French Corsican Pride Bandana Scarf for Hiking
aliexpress.ru
$20.29
Очень большой игровой коврик для мыши Kawaii, настольный коврик XXL, розовый Sakura, компьютерная клавиатура, коврик для ноутбука, аксессуары для стола
aliexpress.ru
$22.86
MOC- 176586 SF-24 красная новая формула, сборка автомобиля, вышивка, модель строительного блока •303, детали MOC, креативная детская игрушка на день рождения, подарок
aliexpress.ru
$760.92
10 шт./лот, новая печатающая головка Honeywell PC43T 300DPI для INTERMEC Honeywell PD43 PD43T PC43T PC43d, детали термопринтера, головка
aliexpress.ru
$150.49
Роскошный креативный Маленький журнальный столик الجالجالج, круглый стол для гостиной, прикроватный мраморный угловой стол Nano Gold
aliexpress.ru
$3.38
10PCS Cartoon Animal Abstract Human Face Nail Sticker Blue Smiley Flame Fruit Nail Tool Black Love Rose Nail Tool
aliexpress.com
$0.59
1 Pair of Keyrings Couple Lover Key Rings Chains Fob Metal Bride Groom Heart Love Keychains Gifts Car Styling Decoration
aliexpress.com
$10.10
Best Quality 750ML Portable Adult Urinal Outdoor Camping Travel Urine Car Urination Pee Soft Toilet Urine Help Men Toilet
aliexpress.com
$400.00
100m 16 Core OCC Silver Plated Semi-finished Earphone headphone Bulk Wire Cable For DIY Repair Custom
aliexpress.com$11.18
KODE D96Q 8 in 1 Gift set Diary journal kit set birthday gift Paket set agenda Buku catatan set lucu
shopee.co.id
$27.72
Per donna Vestito casual Vestito a trapezio Abito stampato Floreale Color Block Stampa A V Vestito longuette Di tendenza Streetwear Interni Giornaliero Mezza manica Morbido Bianco Estate Primavera S
lightinthebox.com
$21.69
Per donna Leggings per lo yoga Fasciante in vita Sollevamento dei glutei Vita alta Yoga Fitness Allenamento in palestra Pantaloni Viola Elastene Gli sport Abbigliamento sportivo Elasticizzato magro
lightinthebox.com
$21.69
Per uomo maglietta Magliette con slogan Leone Croce Templare Stampe astratte A V A B C D E Stampa 3D Esterno Strada Manica lunga Stampa Abbigliamento Essenziale Sportivo Originale Informale
lightinthebox.com
$60.20
Lifelike Silicone Vinyl Reborn Doll Baby 18inch Realistic Cute Babies Dolls With Bodysuit Kids Playmate
aliexpress.com
$6.86
Половинная простая хлопковая ткань с японским кружевом и цветочным принтом для одежды ручной работы «сделай сам», ткань для шитья сумок, 100% ...
aliexpress.ru
$14.45
Книга Compte Rendu Du Deuxième Congrès International Des Mathématiciens: Tenu À Paris Du 6 Au 12 Août 1900
sima-land.ru
$11.91
Книга Awful Disclosures of Maria Monk: As Exhibited in a Narrative of Her Sufferings
sima-land.ru